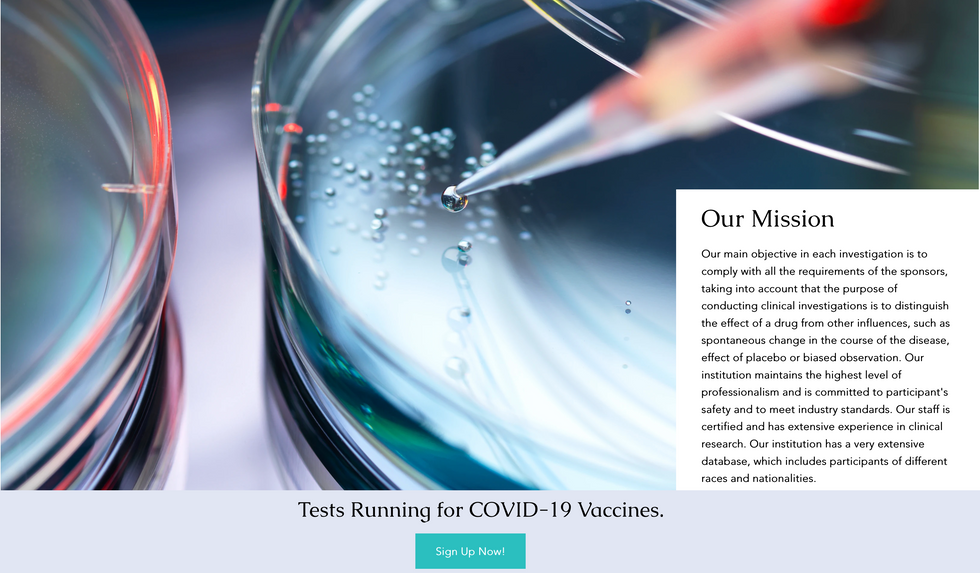
Screenshot 2023-04-11 at 9.20.58 AM

top of page
Create Your First Project
Start adding your projects to your portfolio. Click on "Manage Projects" to get started
Floridian Research Institute
The goal of this project was to create an overall visual concept for Floridian Research Institute that is cohesive, modern, and eye-catching.
The website needed to list out their services and include contact form.

bottom of page

